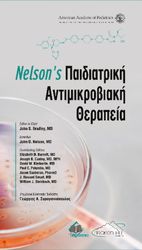
NELSONS ΒΑΣΙΚΗ ΠΑΙΔΙΑΤΡΙΚΗ

🔥 Hot
 ✨ New
✨ New
/columbia-polo-nelson-point-1772721-mple-regular-fit-0000301585329.jpg) ✨ New
✨ New
/columbia-polo-nelson-point-1772721-prasino-regular-fit-0000304693410.jpg) ✨ New
✨ New
/columbia-polo-nelson-point-1772721-gkri-regular-fit-0000301585305.jpg)










/adidas-t-shirt-made-by-nelson-jn7030-mauro-loose-fit-0000304726002.jpg)



/adidas-mplouza-made-by-nelson-v-day-jp0980-mauro-loose-fit-0000304726064.jpg)
/adidas-mplouza-made-by-nelson-v-day-jp0979-gkri-loose-fit-0000304726057.jpg)




🤍
⚖️

adidas Originals
Τσάντα adidas Originals Nelson JD5365 μπεζ ONE SIZE
★★★★★(20)
από
35,99 €
Δες τιμές →
🏪 2 καταστήματα
🤍
⚖️
/columbia-polo-nelson-point-1772721-mple-regular-fit-0000301585329.jpg)
Columbia
Columbia Polo Nelson Point 1772721 Μπλε Regular Fit
★★★★★(449)
από
37,99 €
Δες τιμές →
🏪 2 καταστήματα
🤍
⚖️
/columbia-polo-nelson-point-1772721-prasino-regular-fit-0000304693410.jpg)
Columbia
Columbia Polo Nelson Point 1772721 Πράσινο Regular Fit
★★★★★(51)
από
43,99 €
Δες τιμές →
🏪 2 καταστήματα
🤍
⚖️
/columbia-polo-nelson-point-1772721-gkri-regular-fit-0000301585305.jpg)
Columbia
Columbia Polo Nelson Point 1772721 Γκρι Regular Fit
★★★★★(202)
από
43,99 €
Δες τιμές →
🏪 2 καταστήματα
🤍
⚖️

adidas Originals
Βαμβακερό μπλουζάκι adidas Originals Nelson JC8333 μαύρο L,XL
★★★★★(213)
από
49,90 €
Δες τιμές →
🏪 2 καταστήματα
🤍
⚖️

adidas Originals
Μπλουζάκι adidas Originals Nelson JC8334 μπεζ XL,L
★★★★★(455)
από
49,90 €
Δες τιμές →
🏪 2 καταστήματα
🤍
⚖️

adidas Originals
Βαμβακερή μπλούζα adidas Originals Nelson JC8335 μαύρο XXS,M,L,XL
★★★★★(449)
από
59,90 €
Δες τιμές →
🏪 2 καταστήματα
🤍
⚖️

BOGNER Fire+Ice
BOGNER Fire+Ice σορτς μαγιό ανδρικά NELSON2 14012967 κόκκινο 52,54,46,48,50
★★★★★(210)
από
76,90 €
Δες τιμές →
🏪 2 καταστήματα
🤍
⚖️

NELSON BOB
ΜΗΝ ΑΚΟΥΣ ΤΥΦΛΑ ΤΙΣ ΕΝΤΟΛΕΣ ΠΑΡΕ ΠΡΩΤΟΒΟΥΛΙΕΣ
★★★★★(187)
από
7,89 €
Δες τιμές →
🏪 1 κατάστημα
🤍
⚖️

NELSON MAGGIE
ΟΙ ΑΡΓΟΝΑΥΤΕΣ
★★★★★(237)
από
12,61 €
Δες τιμές →
🏪 1 κατάστημα
🤍
⚖️

NELSON AZUMAH CALEB
ΑΝΟΙΧΤΗ ΘΑΛΑΣΣΑ
★★★★★(428)
από
12,95 €
Δες τιμές →
🏪 1 κατάστημα
🤍
⚖️

NELSON MAGGIE
ΣΠΟΥΔΗ ΣΤΟ ΜΠΛΕ
★★★★★(283)
από
12,96 €
Δες τιμές →
🏪 1 κατάστημα
🤍
⚖️

PENA NELSON
KOBE ΜΑΘΗΜΑΤΑ ΖΩΗΣ ΑΠΟ ΕΝΑΝ ΘΡΥΛΟ
★★★★★(390)
από
15,50 €
Δες τιμές →
🏪 1 κατάστημα
🤍
⚖️

NELSON AZUMAH CALEB
ΜΙΚΡΟΙ ΚΟΣΜΟΙ
★★★★★(564)
από
16,92 €
Δες τιμές →
🏪 1 κατάστημα
🤍
⚖️
/adidas-t-shirt-made-by-nelson-jn7030-mauro-loose-fit-0000304726002.jpg)
adidas
T-Shirt adidas Made by Nelson JN7030 Μαύρο XL
★★★★★(338)
από
25,90 €
Δες τιμές →
🏪 1 κατάστημα
🤍
⚖️

KRAUSE JERRY, CRAIG NELSON
BASKETBALL
★★★★★(487)
από
30,00 €
Δες τιμές →
🏪 1 κατάστημα
🤍
⚖️
ΣΥΛΛΟΓΙΚΟ ΕΡΓΟ
NELSONS ΒΑΣΙΚΗ ΠΑΙΔΙΑΤΡΙΚΗ
★★★★★(468)
από
40,00 €
Δες τιμές →
🏪 1 κατάστημα
🤍
⚖️

HAL LEONARD
GUITAR AEROBICS - BY TROY NELSON B/CD
★★★★★(266)
από
42,00 €
Δες τιμές →
🏪 1 κατάστημα
🤍
⚖️
/adidas-mplouza-made-by-nelson-v-day-jp0980-mauro-loose-fit-0000304726064.jpg)
adidas
Μπλούζα adidas Made By Nelson V-Day JP0980 Μαύρο
★★★★★(345)
από
54,90 €
Δες τιμές →
🏪 1 κατάστημα
🤍
⚖️
/adidas-mplouza-made-by-nelson-v-day-jp0979-gkri-loose-fit-0000304726057.jpg)
adidas
Μπλούζα adidas Made By Nelson V-Day JP0979 Γκρι
★★★★★(501)
από
59,90 €
Δες τιμές →
🏪 1 κατάστημα
🤍
⚖️

BOGNER Fire+Ice
BOGNER Fire+Ice σορτς μαγιό Ανδρικά NELSON2 14012967 μαύρο 46,50,52,54,48
★★★★★(256)
από
76,90 €
Δες τιμές →
🏪 1 κατάστημα
🤍
⚖️

BOGNER Fire+Ice
BOGNER Fire+Ice σορτς μαγιό Ανδρικά NELSON2 14012967 πορτοκαλί 50,52,54,46,48
★★★★★(345)
από
76,90 €
Δες τιμές →
🏪 1 κατάστημα
🤍
⚖️

Levenhuk
Levenhuk Nelson 7x35 Κιάλια
★★★★★(160)
από
79,00 €
Δες τιμές →
🏪 1 κατάστημα
🤍
⚖️

BOGNER Fire+Ice
BOGNER Fire+Ice σορτς μαγιό Ανδρικά NELSON2 14011308 πράσινο 46,48,50,52,54
★★★★★(208)
από
99,90 €
Δες τιμές →
🏪 1 κατάστημα